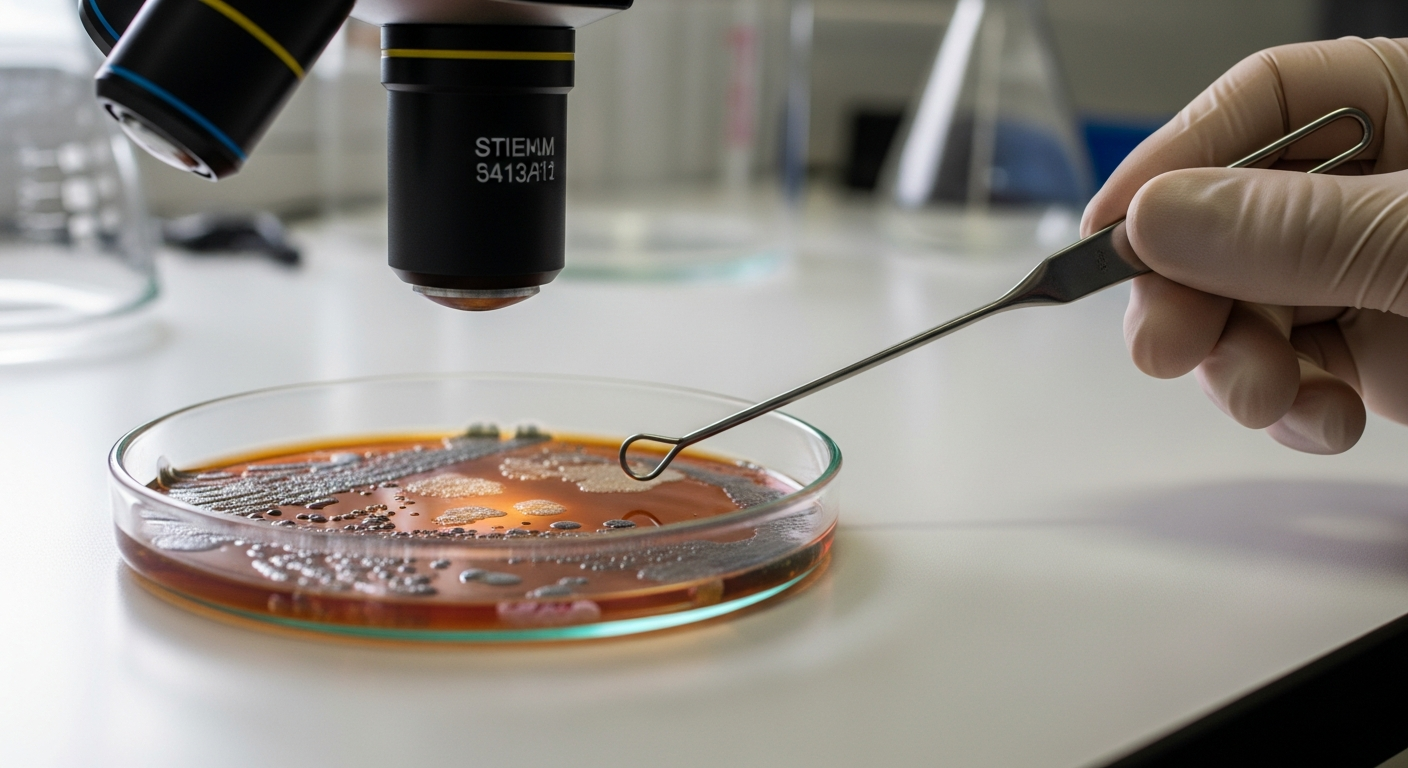

維持腸道平衡的重要性
腸道健康是整體身心健康的重要基石,深刻影響著我們的生活品質。當腸道微生物群處於和諧的平衡狀態時,身體的消化系統、營養吸收效率以及免疫防禦機制都能夠有效且順暢地運作。然而,在現代快節奏的生活方式下,不健康的飲食習慣、高壓環境以及環境因素等,往往會導致腸道微生態失衡,進而引發一系列的消化道不適和更廣泛的健康問題。因此,深入理解並積極採取措施來維持腸道平衡,對於提升個人福祉和有效預防潛在疾病具有不可忽視的重要性。
本文僅供參考,不應被視為醫療建議。如需個人化指導和治療,請諮詢合資格的醫療專業人員。
腸道是人體內一個複雜的生態系統,居住著數以萬億計的微生物,統稱為腸道微生物群。這些微生物在消化食物、合成維生素、調節免疫功能以及保護腸道免受有害病原體侵害方面扮演著關鍵角色。當腸道內的益生菌和有害菌之間保持適當的平衡時,我們的消化系統就能順暢運作,身體也能有效地吸收營養,維持健康的體魄。相反,一旦這種平衡被打破,便可能導致一系列的消化問題和全身性症狀,影響身心健康。
消化系統的運作與腸道健康
人體的消化系統是一個精密的網絡,從口腔開始,經過食道、胃部、小腸和大腸。腸道,特別是小腸和大腸,是食物消化吸收和廢物排泄的核心區域。健康的腸道功能不僅確保食物被有效分解和營養物質被吸收,還能促進規律的排便,避免累積毒素。腸道內壁的完整性也對於阻止有害物質進入血液循環至關重要,這強調了腸道在整體健康中的核心地位。
腸道微生物群與其平衡
腸道微生物群是影響腸道平衡的關鍵因素。一個多樣化且平衡的微生物群有助於維持腸道屏障功能,抵禦感染,並影響情緒和認知功能。當益生菌(有益細菌)數量不足或有害菌過度增殖時,就可能出現腸道失衡,這被稱為生態失調。這種失調可能導致腹脹、腹痛、腹瀉或便秘等腸道不適,甚至與慢性疾病的發展有關。維持腸道微生物群的平衡對於整體身心健康至關重要。
飲食與營養對腸道的影響
飲食是影響腸道健康的直接因素。高纖維、富含益生元和益生菌的飲食有助於支持健康的腸道環境。益生元是膳食纖維的一種,能為腸道益生菌提供養分,促進其生長。而益生菌則是有益的活微生物,可以直接補充腸道內的益生菌數量。全穀物、蔬菜、水果、豆類以及發酵食品(如優格、泡菜、康普茶)都是對腸道有益的食物選擇。適當的營養攝取對於維護腸道功能和腸道平衡至關重要。
常見消化問題及其解決方案
許多人會經歷不同程度的消化問題,例如胃部不適、脹氣、便秘或腹瀉。這些問題可能由多種因素引起,包括飲食不當、壓力、藥物副作用或潛在的健康狀況。針對這些消化問題,可以考慮調整飲食習慣,增加膳食纖維和水分攝取,適度運動,並管理壓力。對於持續或嚴重的問題,尋求醫療專業人員的建議是解決方案的關鍵一步,他們可以提供準確的診斷和個人化的緩解策略。
維護腸道健康的日常實踐
除了飲食,還有其他日常習慣可以支持腸道健康和福祉。規律的體育活動有助於促進腸道蠕動,減少便秘。充足的睡眠對於身體的修復和腸道功能至關重要。有效的壓力管理技巧,如冥想、瑜伽或深呼吸練習,也能減輕壓力對胃腸道的負面影響。此外,避免過度使用抗生素和非類固醇消炎藥,因為它們可能對腸道微生物群造成干擾,也是護理腸道的重要一環。
腸道不適的影響與處理
腸道不適不僅會帶來身體上的困擾,如胃部疼痛或排便困難,還可能影響情緒和日常生活品質。長期的腸道問題,例如腸易激綜合症(IBS)或炎症性腸病(IBD),可能需要更專業的治療和支持。當出現持續性的腸道不適時,應及時諮詢醫生,以確定根本原因並獲得適當的治療方案。透過早期診斷和綜合性的護理,可以有效管理這些症狀,提升生活舒適度。
維持腸道平衡是實現全面健康和福祉的關鍵。透過均衡的飲食、積極的生活方式、有效的壓力管理以及對腸道健康的持續關注,我們可以支持消化系統的順暢運作,增強免疫力,並提升整體的生活品質。了解腸道的複雜性並採取積極措施來護理它,是投資於自身健康的明智之舉。




